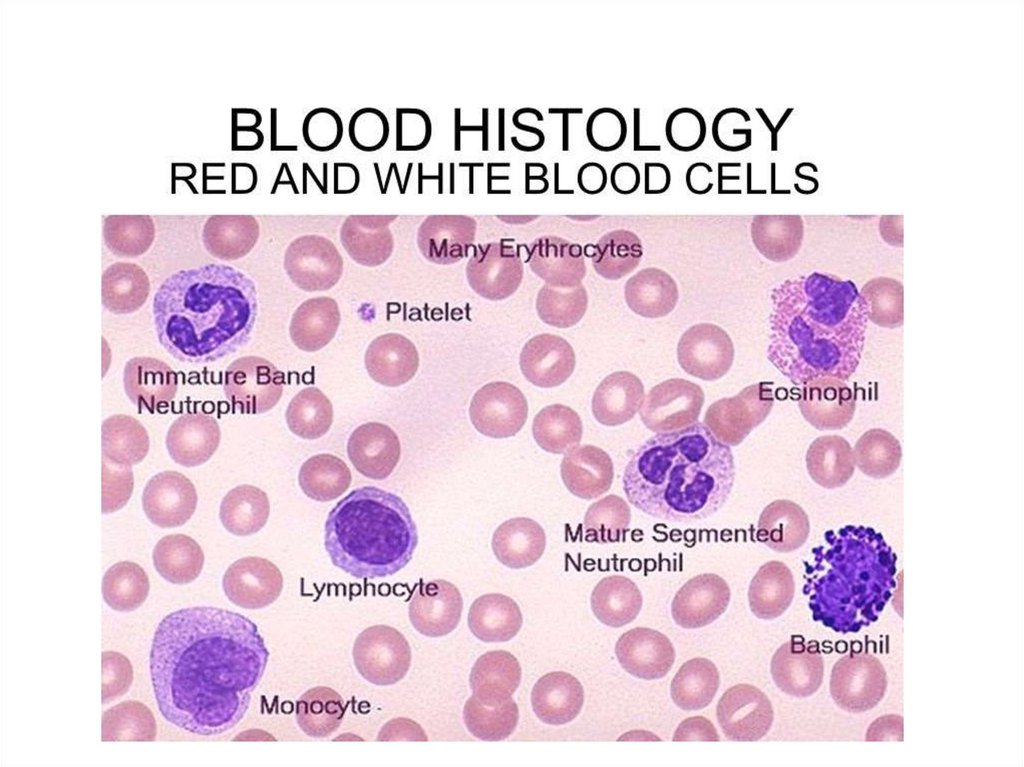
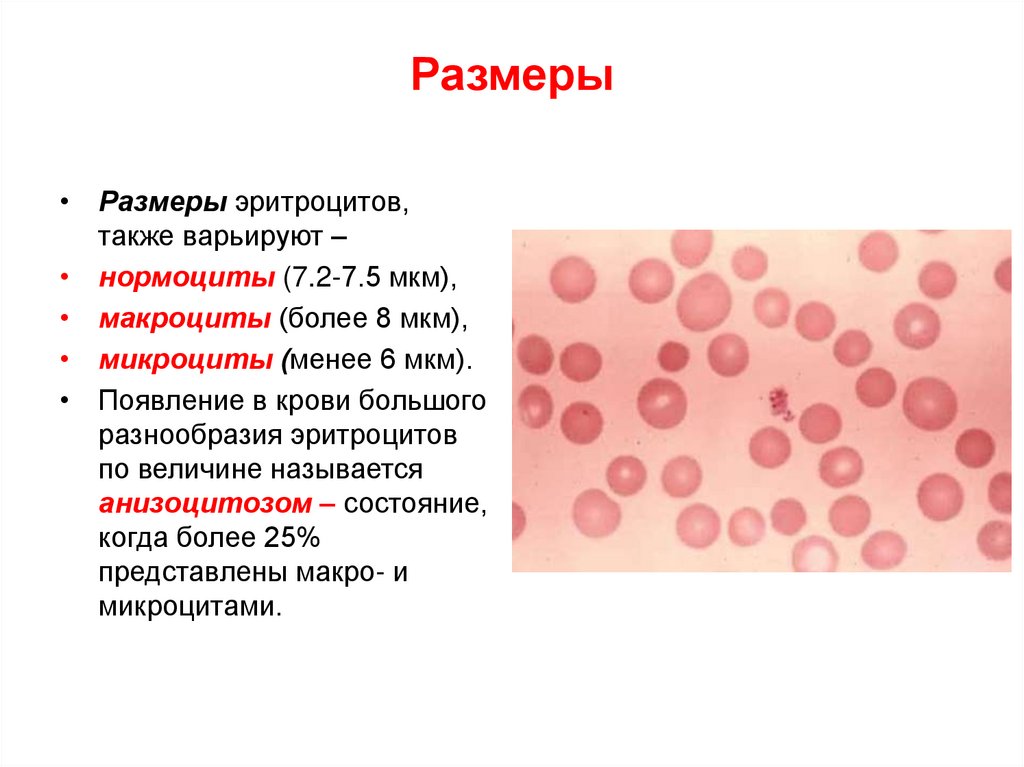
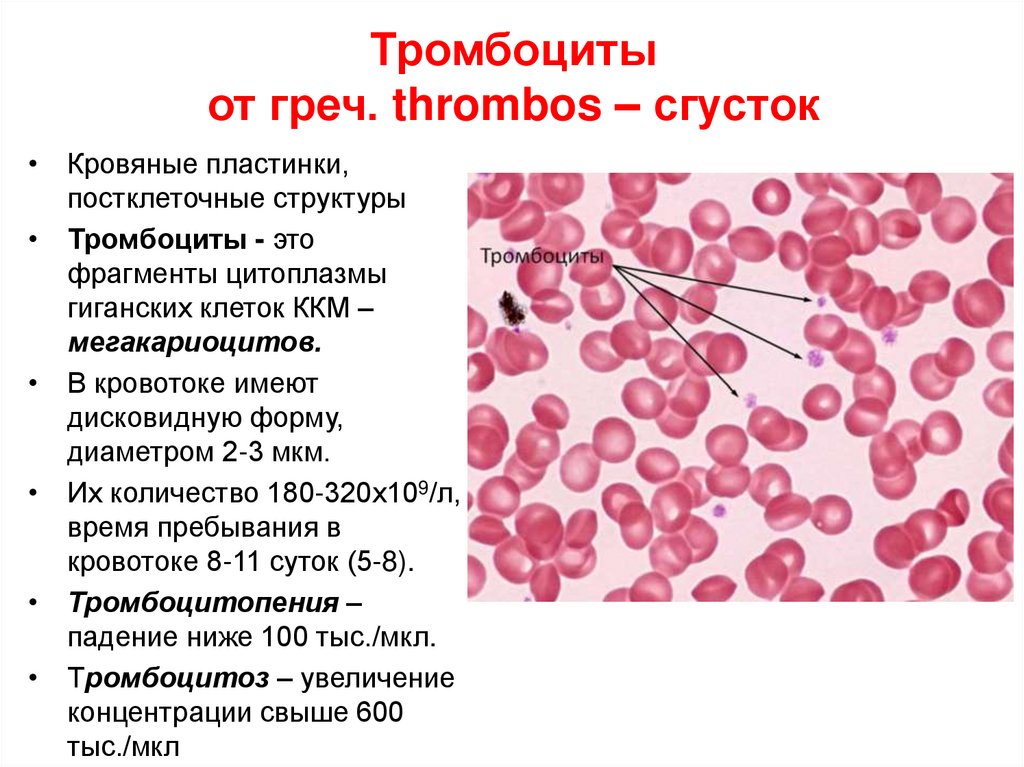

Похожие презентации:
Кровь и лимфа – ткани внутренней среды
1. КРОВЬ И ЛИМФА – ТКАНИ ВНУТРЕННЕЙ СРЕДЫ
СВФУ Медицинский институт: Заведующая кафедрой гистологии имикробиологии, доцент,
к.б.н. Пшенникова Елена Виссарионовна
2. Общие сведения
• Кровь и лимфа относятся к тканямвнутренней среды организма.
• Кровь составляет примерно 1/13 часть массы тела
(5,5 л).
• Кровь является частью сложной системы, в
которую входят органы кроветворения, скопления
лимфоидной ткани в некроветворных органах, а
также клетки крови, выселившиеся в соединительные
и эпителиальные ткани.
• В крови различают 2 компонента:
• плазму (межклеточное вещество) - 55- 60 % объёма
крови (около 3 л)
• форменные элементы - 40-45 % объёма крови.
3. Функции крови
• Транспортную – обеспечивает переносразнообразных веществ
• Дыхательную – перенос газов (О2 и СО2)
• Экскреторную – удаление продуктов метаболизма
• Регуляторную – перенос гормонов, факторов роста
и др. биологически активных веществ,
терморегуляторную – распределение тепла между
органами и его выделение во внешнюю среду
• Гомеостатическую – поддержание постоянства
внутренней среды
• Защитную – нейтрализация чужеродных антигенов,
иммунные реакции
4. Состав крови
Состоит из плазмы и форменных элементов
Форменные элементы:
Эритроциты
Тромбоциты
Лейкоциты
Геммограмма – количественное содержание всех
форменных элементов
• Лейкоцитарная формула - содержание лейкоцитов
в%
5. ПЛАЗМА КРОВИ
• Плазма - светло-жёлтая жидкость.Состав:
• Имеет слабую щелочную реакцию - рН 7,4
• на 90-93% состоит из воды,
• на 7-10% из сухого вещества,
• белки (6,5 - 8,5 %) - альбумины, глобулины и
фибриноген,
• липиды,
• низкомолекулярные органические соединения –
продукты обмена веществ,
• различные неорганические ионы - в свободном
состоянии или связанном со специальными
транспортными белками.
6. Плазма крови
• В плазме всегда присутствуют тканеспецифическиебелки – ферменты, уровень которых изменяется при
заболеваниях и распаде клеток соответствующих
тканей и органов.
• Свыше 100 разновидностей белков плазмы крови в
основном относят к фракциям: альбуминам,
глобулинам, фибриноген.
• Альбумины – преобладающие, переносят
метаболиты, гормоны, ионы, поддерживают
онкотическое давление крови
• Глобулины (ά- и β-) – переносят ионы металлов,
липиды, γ-глобулины – антитела
• Фибриноген – обеспечивает свертывание крови
7. Белки крови
• Альбумины синтезируются в печени,• они поддерживают коллоидно-осмотическое
давление крови (25 мм рт.ст.), их молекулы
привлекают из тканей воду и удерживают ее в
кровотоке.
• При голодании или почечной недостаточности,
приводящей к потере с плазмой альбуминов и других
белков, вода задерживается в тканях и развивается
отеки.
• Альбумины также способствуют растворению плохо
растворимых в воде веществ, адсорбируют и
переносят ряд соединений
8. Белки крови
• Глобулины составляют более тяжелую фракциюбелков, среди них гамма-глобулины являются
антителами и образуются В-лимфоцитами и
плазматическими клетками,
• остальные глобулины синтезируются в печени,
• β-глобулины участвуют в связывании ионов железа,
меди, цинка и др.
• Фибриноген и протромбин, которые обеспечивают
свертывание крови.
• Если дать крови свернуться, то после отделения
сгустка вместо плазмы получается сыворотка
крови. Она отличается от плазмы только
отсутствием фибриногена.
9. Форменные элементы
• эритроциты (красныекровяные тельца) - 5·1012
1/л,
• лейкоциты (белые
кровяные клетки) - 6·109 1/л,
• тромбоциты (кровяные
пластинки) - 2,5·1011 1/л.
• Изучают форменные
элементы в мазках,
окрашенных специальными
красителями (метод
Д.Л.Романовского,
предложенный в 1891 г,
основанный на способности
клеток крови воспринимать
красители азур- II и эозин).
10.
11. Эритроциты (греч. erythros – красный)
• Наиболеемногочисленная группа
форменных элементов
муж. – 3.9-6.0 х 10 12 /л
жен. – 3.7-5.0 х 1012/л
• Не содержат ядра и
органелл
• Содержит гемоглобин
(HbF – фетальный, HbA
– у взрослых)
• Продолжительность
жизни 109-125 суток, на
Севере - 70-90 суток.
12. Строение эритроцита
• Эритроцит не содержит ядра,• заполнен гемоглобином.
• Плазмолемма состоит из белкового-липидного
комплекса, снаружи имеется гликокаликс,
• изнутри прикрепляется филаментами из белка
спектрина, что обеспечивает прочность и гибкость
мембране.
13. Мембрана эритроцита
Интегральные белки: Гликофорины и Полоса 3
Характер гликозирования определяет группу крови.
Периферические белки: Спектрин α и Спектрин β
Нити прикрепляются большими белками
Гликофорин (полоса 4) и Анкирин (полоса 3)
14.
15. Агглютиногены
• Гликокаликс образован олигосахарами всоставе гликолипидов, гликосфинголипидов,
гликопротеидов мембраны.
• Они являются антигенами крови –
агглютиногенами (А, В, Н, и др.) – открыты
Ландштейнером в 1930 г он за это открытие
получил Нобелевскую премию.
• В 1940 г. он обнаружил на поверхности
эритроцита Rh- фактор, который имеется у
85% людей и отсутствует у 15%
16.
17. Гемоглобин
• Гемоглобин – трехмерныйбелок эритроцитов
• Оксигемоглобин – Hb+O2
• Карбгемоглобин
(Carbaminohemoglobin)
Hb+CO2
• Карбоксигемоглобин
Hb+CO=HbCO – очень
стабильный комплекс
• СО связывается с
гемоглобином в 200 раз
активнее (HbCO), чем О2.
• 50% связанных эритроцитов
(HbCO) вызывает смерть
18. Фетальный гемоглобин
• Гемоглобин плодаHbF отличается от
гемоглобина
взрослого человека,
тем, что он обладает
большим сродством в
кислороду, что даем
плоду лучший доступ
к кислороду из
кровотока матери
19. Показатели крови: Эритроциты
• Анемия – снижение содержания гемоглобина• Полицитемия – повышенная концентрация
гемоглобина
• СОЭ – 5-9 мм/ч (2-12 мм/ч) – увеличивается
при инфекционных, воспалительных,
онкологических заболеваниях
20. Форма эритроцита
• Большинство эритроцитов имеют формудвояковогнутого диска – дискоциты (66%), которая
необходима для увеличения поверхности и создания
оптимальных условий для газообмена.
• Кроме того, имеются и другие формы: в виде
колпачка – стоматоциты (18,5%), с шиповатыми
выростами – эхиноциты (5,7%), округлые –
сфероциты (4,2%) и др.
• Изменение формы эритроцитов называется
пойкилоцитозом (греч. poikilos – разнообразный) состояние, когда более 20% имеют измененную
форму.
21. Пойкилоцитоз
22. Размеры
• Размеры эритроцитов,также варьируют –
• нормоциты (7.2-7.5 мкм),
• макроциты (более 8 мкм),
• микроциты (менее 6 мкм).
• Появление в крови большого
разнообразия эритроцитов
по величине называется
анизоцитозом – состояние,
когда более 25%
представлены макро- и
микроцитами.
23.
24. Ретикулоциты
• В норме в кровотоке присутствуют около 1% невполне зрелых, молодых эритроцитов –
ретикулоцитов, имеющих в цитоплазме
небольшое количество рибонуклеопротеидов (синтез
гемоглобина),
• Содержание:
• 0,7-1% - у взрослых,
• 3-5% - у новорожденных,
• 6-7% - у недоношенных
• Число увеличивается при кровопотере.
25. Ретикулоциты
• В мазках они окрашиваются в голубой цвет, виднасетчатая структура (митохондрии, рибосомы,
центриоли, КГ).
26.
27. Функции эритроцита
• Дыхательная – транспорт О2 и СО2.• Регуляторная и защитная - могут переносить на
своей поверхности антитела, токсины, аминокислоты,
протеины, участвуют в образовании тромбов.
• Транспорт веществ – гормонов,
иммуноглобулинов, лекарственных веществ,
токсинов и др.
• На поверхности имеют рецепторы групп крови и
резус-фактора
28. Тромбоциты от греч. thrombos – сгусток
• Кровяные пластинки,постклеточные структуры
• Тромбоциты - это
фрагменты цитоплазмы
гиганских клеток ККМ –
мегакариоцитов.
• В кровотоке имеют
дисковидную форму,
диаметром 2-3 мкм.
• Их количество 180-320х109/л,
время пребывания в
кровотоке 8-11 суток (5-8).
• Тромбоцитопения –
падение ниже 100 тыс./мкл.
• Тромбоцитоз – увеличение
концентрации свыше 600
тыс./мкл
29. Тромбоциты
• Гиаломер – по периферии• Грануломер – в центре
• Различают 5 видов
тромбоцитов:
• юные (4,2%),
• зрелые (88%),
• старые (4,1%),
• дегенеративные (до 2%),
• гигантские (2%).
• на плазмолемме имеется
рецептор к фрагментам
антител, к С3-компоненту
комплемента плазмы крови,
антиген тромбоцитов,
антигены групп крови и
резус-антиген
Обновление 15%,
2/3 циркулируют в кровотоке,
1/3 – в селезенке
30. Строение тромбоцита
Гиаломер – содержит по
периферии спираль из
микротрубочек и актиновые
микрофиламенты, имеет
инвагинации в виде внутренней
системы канальцев, по ней
транспортируются частицы,
ионы кальция и др.
Грануломер – содержит
гранулы:
α-гранулы – фибриноген,
плазминоген, ФРТ (свертывание
крови, агрегация тромбоцитов,
ферменты: кислая фосфатаза,
катепсин, тромбокиназа, фактор
свертывания крови)
δ гранулы (дельта) – плотные тельца
(серотонин, ионы кальция, АТФ, АДФ,
фибриноген, до десяти факторов
свертывания крови)
λ-гранулы (лямбда)– лизосомы
(резорбция сгустка)
31. Функции тромбоцитов
• Участвуют всвертывании крови;
• Снижают
проницаемость
капилляров;
• Транспортируют на
поверхности антитела;
• Удаляют из кровотока
инородный материал
путем фагоцитоза.
32. Лейкоциты – от греч. leukos - белый
• 4.0-10.0 х 109/л• Зернистые
(гранулоциты):
содержат пнрвичные и
специфические
гранулы (нейтрофилы,
эозинофилы,
базофилы)
• Незернистые
(агранулоциты):
содержат первичные
(азурофильные)
гранулы – лизосомы
(лимфоциты,
моноциты)
33. Первичные (азурофильные) гранулы
• Миелопероксидаза – генерирует токсичные длябактерий вещества (гипохлорит, хрорамин)
• Дефензины – связываются и образуют дыры на
клеточных мембранах микроорганизмов
• Кателицин – разрушает мембраны микробов при
фагоцитозе бактерий
• Лизоцим – расщепляет клеточную стенку бактерий.
• Кислые гидролазы – гидролизуют органические
молекулы
34. Нейтрофильный гранулоцит
• Являются активнымифагоцитами
• Первыми мигрируют в очаг
инфекции
• Первичные гранулы
• Специфические – щелочная
фосфотаза, коллагеназа,
бактерицидные ферменты,
белок связывающий вит. В12,
желатиназа, эластаза и др.
• Продолжительность жизни –
циркулируют – 6-7 ч, в тканях
– 1-2 сут. (5-8 сут.)
• Размеры - в мазке 10-15 мкм.
У взрослых - 65-70% от числа
лейкоцитов,
У детей (от новорожденного до 4-5
лет) – 25%,
У женщин - тельце Барра – половой
хроматин.
35.
36. Миграция нейтрофилов
• 1 фаза – Е – селектин и Р-селектин распознаются наповерхности эндотелиальных клеток и
взаимодействует с нейтрофилами
• 2 фаза – нейтрофилы связываются поверхностью с
помощью интегринов
• Диапедез – выход из сосуда – нейтрофил
протягивает псевдоподии между клетками эндотелия
(парацеллюлярный путь) или через поры в эндотелии
(трансцеллюлялный путь)
37.
38.
39. Рецепторы нейтрофилов для взаимодействия с патогенами
• Рецепторы Fc – связываются с областью Fc антителIgG на поверхности бактерий и способствуют их
фагоцитозу
• Рецепторы комплемента CR- связывают антигенантитело
• Рецепторы скавенджеров SR- связываютс грамм+ и
грамм – бактерий и апоптозых телец
• Toll-подобные рецепторы (образ-распознающие
рецепторы связываются с патогенными
молекулярными структурами, которые
экспрессируются на бактериальных поверхностях и
др. инфекционных агентах.
40. Кислородозависимое убийство
• Во время фагоцитоза нейтрофилы потребляютбольше кислорода, это называется кислородным
взрывом.
• Это приводит к синтезу нескольких
кислородсодержащих соединений, с помощью
• НАДФН-оксидазы (встроена в мембрану)
• Миелопероксидазы (первичные гранулы)
• Процесс при котором нейтрофилы убивают
микрооганизмы называется кислородозависимым
уничтожением
41. Внеклеточные ловушки нейтрофилов
• В качестве последней линии защиты нейтрофилыумирают, используя свои молекулы ДНК для
образования внеклеточных ловушек для
иммобилизации бактериальных клеток. Сети состоят
из обработанного хроматина, пропитанного
ядовитыми ферментами
42.
«Сдвиг влево» характеризуется тем, что увеличивается количествомолодых и незрелых форм нейтрофилов.
При острых гнойно-воспалительных заболеваниях, помимо
лейкоцитоза, возрастает содержание молодых форм нейтрофилов,
обычно палочкоядерных, реже - юных нейтрофилов (метамиелоцитов
и миелоцитов), что указывает на серьёзный воспалительный процесс.
43.
44.
Функции:Уничтожение микроорганизмов – они являются
элементами неспецифической защиты, способны к
фагоцитозу (микрофаги).
Разрушение и переваривание поврежденных клеток и
тканей – они первыми прибывают в очаг воспаления.
Участие в регуляции других клеток (благодаря
выработке цитокинов), участие в неспецифических и
специфических иммунных реакциях, микрофаги
45. Базофильный гранулоцит
• Составляют• 0,5-1% от числа
лейкоцитов,
• Продолжительность
жизни - в кровотоке
находятся 48 ч, в тканях
погибают быстро.
• Размеры: в мазке 10-12
мкм.
46. Строение базофила
• Ядро лопастное,• органеллы малочисленны
• метахроматичные гранулы
(около 400) - специфические
гранулы (диаметром 1,5 мкм) содержат пероксидазу,
гепарин, гистамин,
анафилаксин, АТФ,
простагландин,
хематоксический фактор Э и Н)
• неспецифические гранулы содержат протеолитические
ферменты
47.
• Гепарин – универсальный антикоагулянт, механизмдействия гепарина связан с блокированием факторов
свертывания крови, активацией антикоагулянтной
системы, препятствует свертыванию крови,
предотвращает образование сгустков и фибрина,
• Гистамин повышает проницаемость основного
вещества соединительной ткани, способствует
развитию отеков, воспаления, расширяет стенки
кровеносных сосудов.
• Эозинофильный хемотаксический фактор –
привлекает Эо, которые инактивируют гистамин
• Содержит ИЛ-4, ИЛ-13 (синтез IgE), лейкотриены
(сужают кровеносные сосуды)
• Фактор активирующий тромбоциты (ФАТ)
48. Базофил
• На плазмолемме базофилы имеют рецепторы кJgЕ, способны связываться с аллергеном, в
результате гранулы выходят из клеток
(дегрануляция).
• Проявлением этого могут быть высыпания, волдыри,
отеки и удушье – аллергические реакции вплоть до
анафилактического шока и смерти.
• Как и другие гранулоциты они способны к фагоцитозу
и образованию биооксидантов.
49.
• Регуляторная игомеостатическая выделяют биологически
активные вещества
(гистамин, гепарин и др.),
участвуют в синтезе и
выделении этих веществ.
• Защитная – путем
локальной секреции
медиаторов воспаления,
хемотоксических
факторов эозинофилов и
нейтрофилов,
обеспечивают вовлечение
ряда клеток в защитные
реакции организма.
50. Эозинофильный гранулоцит
• Составляют 0,5-5%• Функция – участие в
противопаразитарной
защите
• Специфические гранулы –
• Кислую фосфотазу
• Основной белок (аргинин) убивает бактерии, разрушает
кутикулу паразитов
• Нейротоксин
• Гистаминаза и
арилсульфатаза –
нейтрализуют гистамин
• Продолжительность
жизни - в крови 7-12 ч, в
тканях 8-12 суток.
• Размеры: в мазке 12-17 мкм.
51.
52. Функции эозинофила
• Обладают хемотаксисом к гистамину, лимфокинам(медиаторам лимфоцитов, комплексам антиген-антитело).
• Способны фагоцитировать и накапливать гистамин,
• Вырабатывают фактор тормозящий выброс гистамина
базофилами и тучными клетками,
• Участвуют в противопаразитарной защите.
• При контакте с паразитами выделяют на их поверхности
ферменты, катионные белки и биооксиданты, способные
разрушать кутикулу.
• При аллергических реакциях, гельминтозах содержание
эозинофилов в крови повышается
• Ограничение местных воспалительных реакций
• Участие в обезвреживании ядов и токсинов.
53. Лимфоциты
Составляют 20-40% от числа лейкоцитов
У новорожденных – как у взрослых
С 3-6 дней до 4-5 лет – повышенное
1-2 года – 65%
Продолжительность жизни - от нескольких дней
до десятков лет
• Размеры: подразделяются на малые (4,5-6 мкм),
средние (7-10 мкм) и большие (свыше 10 мкм),
• Функции: обеспечение иммунных реакций, защита от
всего чужеродного.
54. Строение лимфоцита
• Имеют крупноеядро,
• Хроматин
конденсирован,
• Небольшой ободок
цитоплазмы,
• Мало
митохондрий,
грЭПС, КГ,
• мелкие лизосомы
55. Лимфоциты
Классификация по функциональному признаку в соответствии с
поверхностными молекулами:
Т-лимфоциты - 60% экспрессируют рецептор TCR
Т-хелперы (CD4+) – способствуют пролиферации и
дифференцировке других лимфоцитов,
Т-регуляторные клетки (супрессоры) – угнетают функции разных
лимфоцитов посредством медиаторов (лимфокинов).
Т-киллеры (CD8+) – цитотоксические, при воздействии на клеткимишени вызывают лизис (гранзимы), действуют против опухолевых
клеток, инфицированных вирусом клеток, отторгают
трансплантированные ткани
– подавляют иммунный ответ
γδ Т-клетки – интраэпителиальные лимфоциты (не рециркулируют)
В-лимфоциты – синтезируют антитела, экспрессируют рецепторы
IgG, IgM
Естественные киллеры (NK) – против опухолевых клеток, клеток
инфицированных вирусом.
56.
57.
58. 2 перекреста лейкоцитарной формулы
59. Строение моноцита
• Составляют - 3-11%• Продолжительность жизни в кровотоке - 12-32 ч, в тканях до 1 месяца.
• Размеры: диаметром 18-22 мкм
• Строение. Имеют округлую
форму, овальное (бобовидное)
ядро с 1-2 ядрышками,
• Цитоплазма слабобазофильная,
• Лизосомы, неспецифическую
зернистость (ферменты:
неспецифическая эстераза,
лизоцим, пероксидаза).
60.
61.
62. Функции моноцита
• Обладают высокой фагоцитарной активностью,• являются источниками макрофагов различных органов
(легких, костного мозга, лимфатических узлов, селезенки,
соединительной ткани, печени, микроглия, остеокласты и др.).
• являются антиген-представляющими клетками - благодаря
рецепторам на плазмолемме способны фиксировать антигены,
фагоцитировать или перерабатывать их (процессинг), далее
этот антиген способен распознаваться Т-лимфоцитами.
• Запуск реакции специфического иммунитета
• Регуляторная – на кроветворение, активность лейкоцитов,
течение воспалительных реакций (выделяют хемотаксические
факторы, ферменты, медиаторы и др.).
63.
64. Лимфа От греч. Lympha – чистая влага
• Плазма лимфы – по концентрации и составусолей близка к плазме крови (рН 8,4-9,2)
• Форменные элементы:
• 90% лимфоциты,
• 5% - моноцитов,
• 2% - эозинофилов,
• 1% - сегментоядерных нейтрофилов,
• 2% - др.клеток
65. Лимфа: функции
• Гомеостатическая – постоянство микроокружения• Метаболическая – регуляция обмена веществ,
транспорт метаболитов, белков, ферментов, воды,
минеральных веществ, биологически активных
веществ
• Трофическая – транспорт питательных веществ
• Защитная – участие в иммунных реакциях,
транспорт антител, лимфоцитов, макрофагов
66. Кроветворение
Эмбриональный ипостэмбриональный гемопоэз
67. КРОВЕТВОРЕНИЕ (ГЕМОПОЭЗ)
Эмбриональный гемопоэз, который происходит в
эмбриональном периоде в различных органах и
приводит к развитию крови как ткани
• Постэмбриональный гемопоэз, который
представляет собой процесс физиологической
регенерации крови, происходит после рождения в
красном костном мозге
68. Эмбриональный гемопоэз
• 1 стадия (3-9 неделя) – мегалобластический, встенке желточного мешка, интраваскулярно,
первичные эритроциты, I генерация СКК.
• 2 стадия (от 5-й недели) – печеночный (печень,
тимус, лимфоузлы, селезенка), экстраваскулярно.
Гемопоэтические клетки мигрируют из мезодермы
аорто-гонадо-мезонерального региона (из стенки
желточного мешка), вторичные эритроциты,
гранулоциты, лимфоциты, II генерация СКК.
• 3 стадия от 10-й недели – медуллярный, в красном
костном мозге, III генерация СКК, все форменные
элементы.
69. Эмбриональный гемопоэз
70. I стадия - кроветворение в стенке желточного мешка
• начинается в конце 2-й и начале 3-й недели эмбриогенеза.• В мезенхиме стенки желточного мешка обособляются кровяные
островки, где клетки округляются и преобразуются в
стволовые клетки крови (СКК).
• Часть клеток дифференцируется в бласты, большинство
которых делятся (митоз) и превращаются в мегалобласты,
при этом сначала образуются полихроматофильные
эритробласты, а затем оксифильные.
• Такой тип кроветворения называется мегалобластический.
• Развитие первичных эритроцитов в стенке желточного
мешка происходит интерваскулярно.
71.
72. II стадия - кроветворение в печени, тимусе, лимфоузлах, селезенке
• Кроветворение в печени - печень закладывается на3-4 неделе эмбриогенеза, а на 5 неделе становится
центральным кроветворным органом.
• Кроветворение происходит экстраваскулярно.
• Источниками кроветворения становятся стволовые
клетки (из желточного мешка), из которых образуются
бласты, дифференцирующиеся во вторичные
эритроциты. Так же в печени образуются
зернистые (гранулоциты) лейкоциты
(эозинофилы и нейтрофилы) и мегакариоциты.
• Кроветворение в печени завершается к концу
внутриутробного периода.
73.
Кроветворение в тимусе
Тимус закладывается к концу 1-го месяца эмбриогенеза.
Заселение СКК происходит на 7-8 неделе,
далее происходит дифференцировка в Т-лимфоциты.
Кроветворение в лимфатических узлах
Лимфатические узлы закладываются на 7-8 неделе,
развиваются и заселяются СКК на 9-10 неделе эмбриогенеза.
На ранних стадиях СКК дифференцируются в эритроциты,
гранулоциты и мегакариоциты. Появление первых лимфоцитов
происходит на 8-15 недели развития, а их массовое заселение
предшественниками Т- и В-лимфоцитами с 16 недели.
Кроветворение в селезенке
Селезенка закладывается в конце 1-го месяца эмбриогенеза.
Является универсальным кроветворным органом, т.к. в ней
экстраваскулярно образуются все форменные элементы
крови.
Образование эритроцитов и гранулоцитов достигает максимума
на 5-м месяце эмбриогенеза, после этого преобладает
лимфоцитопоэз.
74. Кроветворение в костном мозге
• ККМ закладывается на 2 месяце эмбриогенеза,первые гемопоэтические клетки появляются на 12
неделе развития, основная масса представлена
эритробластами и предшественниками гранулоцитов.
• из ССК формируются все форменные элементы
крови, развитие которых происходит
экстраваскулярно.
75. Постэмбриональное кроветворение
• Миелопоэз происходит в миелоидной ткани,расположенной в эпифизах трубчатых костей и
полостях губчатых костей. Здесь развиваются
эритроциты, гранулоциты, моноциты, тромбоциты ,
предшественники лимфоцитов.
• Лимфоцитопоэз происходит в лимфоидной ткани
(тимусе, лимфатических узлах). Она выполняет
основные функции: образование Т- и В-лимфоцитов
и плазмоцитов.
76.
77. Постэмбриональный гемопоэз
• Миелоидная и лимфоидная ткани относятся к тканямвнутренней среды.
• В них представлены две основные линии – клетки
ретикулярной ткани и гемопоэтические.
• Ретикулярные клетки, а также жировые, тучные и
остеогенные с межклеточным веществом формируют
микроокружение, которое воздействует на
дифференцировку клеток крови.
78. Стадии развития клеток составляют VI компартментов:
• I- стволовые клетки крови (СКК)• являются мультипотентными (полипотентными)
предшественниками всех клеток крови (CD34+,
CD90+, CD38-, Lin-)
• Способна дифференцироваться во все типы клеток
крови
• Количество небольшое 10-4 – 10-5
• Самоподдерживающеяся популяции клеток.
• Редко делятся, находятся в периоде G0.
• впервые представление о родоначальных клетках
крови сформулировал в начале XX в. А. А. Максимов.
• выявление СКК стало возможным при применении
метода колониеобразования.
79.
• II- коммитированные родоначальные(полипотентные) - ПСК
• являются коммитированными, или частично
детерминированными:
• возможности дальнейших превращений для каждой
из них уже ограничена.
• сохраняют возможность дифференцироваться по
двум направлениям.
• чувствительны к регуляторам гемопоэза
(гемопоэтинами), определяющим направление
дифференцировки.
• Виды полустволовых клеток:
• КоЕ-ГЭММ
• КоЕ-Л
80.
• III- коммитированные родоначальныеолигопотентные и унипотентные клетки;
• клетка этого класса может развиваться только по
одному направлению.
• по числу разных видов форменных элементов крови
имеются 8 видов унипотентных клеток предшественники
• КоЕ-Э, КоЕ-Гн, КоЕ-М, КоЕ-Мц, КоЕ-Л – до
предшественников В-лимфоцитов и Т-лимфоцитов.
81.
82.
• IV- молодые клетки-предшественники (бласты)• изменяется морфология клеток (за счёт начала
специфических синтезов):
• большой размер, светлое ядро и светлая
цитоплазма, в цитоплазме первых продукты
специфических синтезов.
• бластные клетки морфологическически практически
неразличимы.
• не способны к самоподдержанию, при их делениях
образуются только более дифференцированные
клетки,
• клетки, подобные родительским, не воспроизводятся.
83.
84.
• Класс V дифференцирующиеся (созревающие)гемопоэтические клетки
• почти в каждом из 6 направлений миелопоэза
представлен не одной клеточной формой, а целым
рядом последовательно переходящих друг в друга
клеток.
• имеются чёткие морфологические отличия
• каждая из клеток этого класса морфологически
идентифицирована.
• Класс VI- зрелые клетки
• В конечном счёте, дифференцировка клеток
приводит к образованию дифференцированных
клеток, т.е. клеток класса VI, или зрелых форменных
элементов крови.
85.
86. Эритропоэз
• 1 СКК делится за 7-10 дней 12 раз и дает 2000эритроцитов
• В условиях гипоксии в почках синтезируется
эритропоэтин.
• Эритропоэтин влияет на КОЭ-Э и дифференцировку
87.
88.
89. Тромбоцитопоэз
СКК
Общий миелоидный предшественник (ПСК)
Предшественник Мегакариоцита/Эритроцитов
КОЕ-Мег (CFU-Meg) - унипотентная клетка
Мегакариобласт (делятся, чувствительно к тромбопоэтину)
Промегакариоцит
Мегакариоцит (полиплоидия, до 64n)
Тромбоциты
90.
91.
• Демаркационная мембранная система представляет собоймножественные инвагинации плазматической мембраны внутри
цитоплазмы мегакариоцита
92.
93.
94.
95. Красный костный мозг
• Синусоиды(трансцеллюлярный
диапедез)
• Строма из
ретикулярной ткани
• Клетки разных ростков
образуют островки
(гнезда)
• Островки эритропоэза
образуются вокруг
макрофагов
• С возрастом ККМ
замещается жировой
тканью (желтый
костный мозг)

Медицина
Медицина








